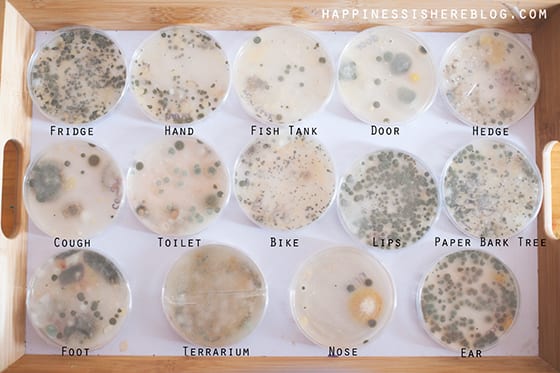
Growing Bacteria Experiment Collection of petri dishes growing mold, labeled fridge, hand, fish tank, and more

Want to see your students’ eyes light up? Tell them they’re going to do an experiment! These 3rd grade science projects are easy enough for any classroom or kitchen, and they’re full of science concepts kids need to learn.
To make things even easier, we’ve rated every one of these 3rd grade science experiments based on difficulty and materials:
Difficulty:
- Easy: Low or no-prep experiments you can do pretty much any time
- Medium: These take a little more setup or a longer time to complete
- Advanced: Experiments like these take a fairly big commitment of time or effort
Materials:
- Basic: Simple items you probably already have around the house
- Medium: Items that you might not already have but are easy to get your hands on
- Advanced: These require specialized or more expensive supplies to complete
Jump to:
- 3rd Grade Science Fair Projects
- 3rd Grade STEM Challenge Projects
- Magnet and Electricity Science Experiments for 3rd Grade
- More 3rd Grade Science Projects and Activities
3rd Grade Science Fair Projects
Use these ideas to build a 3rd grade science fair project. Form your own hypothesis, alter the variables, and see what happens!
Discover the chemistry of slime
Difficulty: Easy / Materials: Medium
Kids adore slime, and it’s actually a terrific way to teach them about polymers. Learn the basics of slime chemistry, then experiment with the formula to make your own unique concoctions.
Make sun prints to display
Difficulty: Easy / Materials: Medium
You’ll need special sun-print paper for this project, but it’s inexpensive and easy to find. Kids learn about chemical reactions as they use the power of the sun to create unique works of art.
Experiment with ice, salt, and water temperature

Difficulty: Easy / Materials: Basic
This simple experiment requires only water, ice, salt, and a thermometer. Your 3rd grade science class can explore how ice and salt affect the temperature, a simple but effective lesson on heat transfer and freezing points.
Learn more: Ice, Salt, and Temperature at 123 Homeschool 4 Me
Experiment with colors

Difficulty: Easy / Materials: Medium
Play around with colors, mix them together, and then use a little science magic to pull them apart again. This chromatography science project requires only simple supplies like coffee filters and markers.
Learn more: Chromatography at 123 Homeschool 4 Me
Understand the science behind bath bombs

Difficulty: Medium / Materials: Medium
Bath bombs certainly make bath time more fun, but what makes them work? Explore chemical reactions and get squeaky clean all at the same time!
Learn more: Bath Bomb Science at Learning Hypothesis
Investigate the effects of erosion

Difficulty: Easy / Materials: Basic
Compare the effects of “rain” on hills of bare soil vs. those covered with grass. Have your 3rd grade science students predict which they think will stand up to erosion better and then test their hypotheses.
Learn more: Erosion Experiment at Third Grade Thinkers
Give flowers a glow-up

Difficulty: Easy / Materials: Medium
This one will make kids’ eyes pop out of their heads! Use highlighters and a black-light flashlight to reveal the vascular system of flowers.
Learn more: Plant’s Vascular System at Tamara “Tamawi” Horne
Grow bacteria from common surfaces
Difficulty: Medium / Materials: Medium
There’s never been a better time to learn about the way germs spread! Take samples from a variety of surfaces, then watch bacteria grow in petri dishes just like grown-up scientists.
Learn more: Growing Germs at Happiness Is Here
Take friction for a ride
Difficulty: Medium / Materials: Medium
Your students will love pulling their way across the floor as they discover more about friction and its effects on motion. Build your own “sled” or use a premade box or tray.
Craft fossils from glue

Difficulty: Easy / Materials: Medium
Create clay molds of natural objects, then fill them with school glue to make your own “fossil” casts. This is a great project to try before a trip to the natural history museum.
Learn more: Glue Fossils at Education.com
Go green with recycled paper

Difficulty: Medium / Materials: Medium
We talk a lot about recycling and sustainability these days, so show kids how it’s done! Recycle old worksheets or other papers using screen and picture frames.
Learn more: Recycled Paper at Undercover Classroom
Filter sediment from dirty water

Difficulty: Easy / Materials: Basic
Explore sediments and water filtration with this easy 3rd grade science experiment. It’s a fun way to learn more about the water cycle.
Learn more: Water Filtration at Teach Beside Me
Put together a compost bottle

Difficulty: Easy / Materials: Basic
Learn about the decomposition of food and how composting can provide nutrients for growing more food with this easy earth science project.
Learn more: Soda Bottle Compost at Busy Mommy Media
Sprout new potatoes
Difficulty: Easy / Materials: Basic
Potatoes grow from tuberous roots, and under the right conditions, new shoots appear from those roots. This 3rd grade science experiment explores the biological science behind cloning.
Use flowers to learn about acid rain

Difficulty: Easy / Materials: Basic
Have you ever wondered what happens to plants when they are exposed to acid rain? Your students can find out by conducting a simple acid rain experiment using flowers and vinegar!
Learn more: Acid Rain Experiment at Little Bins for Little Hands
Keep apples from turning brown

Difficulty: Easy / Materials: Basic
What’s the best method to keep sliced apples from turning brown? Find out with this popular 3rd grade science project.
Learn more: Apple Browning at Teach Beside Me
Fizz it up with antacid
Difficulty: Easy / Materials: Basic
Fizzy fantastic fun! Learn about chemical reactions by mixing water and effervescent antacid tablets to see what happens, comparing the time it takes for whole tablets and small pieces.
Drop objects to learn about gravity
Difficulty: Easy / Materials: Basic
Do heavier objects fall faster than lighter ones? Try this hands-on gravity activity for 3rd graders to find out!
3rd Grade STEM Challenge Projects
Use these STEM challenges as the basis for science fair project ideas, or try them as in-class science activities your 3rd graders will love!
Design a candy-delivery machine

Difficulty: Easy / Materials: Basic
Learn about inclined planes with this fun simple-machines project. Kids can get creative and develop any kind of delivery system they like!
Learn more: Candy Machine at 123 Homeschool 4 Me
Determine the most waterproof roof

Difficulty: Easy / Materials: Basic
Calling all future engineers! Build a house from LEGO, then experiment to see what type of roof prevents water from leaking inside.
Learn more: Waterproof Roof at Science Sparks
Run marble races with pool noodles

Difficulty: Easy / Materials: Medium
Crack open a pool noodle or two and create your own marble racetracks. Experiment with angles, force, and surface materials to find the fastest way to get the marble to the bottom. (Find more fun ways to use pool noodles in the classroom here.)
Learn more: Pool Noodle Marble Races at The Techy Teacher
Build a better umbrella

Difficulty: Easy / Materials: Basic
Challenge students to engineer the best possible umbrella from various household supplies. Encourage them to plan, draw blueprints, and test their creations, using the scientific method.
Learn more: Best Umbrella STEM Challenge at Raising Lifelong Learners
Construct a marshmallow catapult

Difficulty: Easy / Materials: Basic
Fling some sweet treats in the name of science! All you need is an old tissue box, pencils, rubber bands, and a few other supplies to learn about trajectory, air resistance, gravity, and more.
Learn more: Tissue Box Catapult at Frugal Fun for Boys and Girls
Blow through a water whistle

Difficulty: Easy / Materials: Basic
Learn about the science of sound with this easy experiment. Kids will love building their own whistles from straws and a glass of water.
Learn more: Water Whistle at My Baba
Step through an index card

Difficulty: Easy / Materials: Basic
With carefully placed scissor cuts on an index card, you can make a loop large enough to fit a (small) human body through! Kids will be wowed as they learn about surface area.
Learn more: Index Card Experiment at Mess for Less
Construct a Hero’s engine
Difficulty: Medium / Materials: Basic
Sir Isaac Newton came up with rules about how things work in the world. One of these rules is called Newton’s third law. It says that “for every action, there is an equal and opposite reaction.” Do an experiment with your 3rd graders to learn more about this rule!
Model the effect of air drag
Difficulty: Easy / Materials: Basic
To learn about the role of drag in flight, students can fold paper planes in different styles and observe how these changes affect the distance and flight pattern of the planes. Turn this 3rd grade science project into a fun competition to see which plane flies the farthest or stays in the air the longest.
Put together an anemometer
Difficulty: Medium / Materials: Basic
This very simple weather instrument is easy enough for kids to build, allowing them to observe and think like a real meteorologist.
Magnet and Electricity Science Experiments for 3rd Grade
These shocking (OK, not literally!) electricity experiments will fit nicely into many 3rd grade science curriculum programs. Give them a try in the classroom, or encourage an interest in science at home.
Assemble a simple circuit

Difficulty: Medium / Materials: Medium
To test the conductivity of different materials, your students can use a simple electric circuit. Invest in a few of these inexpensive gadgets to allow for all kinds of 3rd grade science projects.
Learn more: Simple Circuits at Science Projects
Turn a safety pin into a circuit
Difficulty: Medium / Materials: Medium
Looking for an even easier simple circuits project? This one requires only a few supplies you can grab at the hardware store and an ordinary everyday safety pin.
Investigate how liquids affect magnets
Difficulty: Easy / Materials: Medium
Are magnets equally effective in water? What about oil or a thicker liquid like, say, a milkshake? This would make for an easy 3rd grade science fair project that’s fun too.
Ask a magnet to dance
Difficulty: Easy / Materials: Basic
This is so cool! Make a magnet dance without touching it in this activity that’s part STEM challenge, part magnet experiment, and 100% amazing.
Capture lightning in a bottle
Difficulty: Medium / Materials: Medium
Well, it’s not quite that dramatic, but this cool electricity experiment for 3rd grade will still wow your students.
Separate salt and pepper with static electricity

Difficulty: Easy / Materials: Basic
When you mix up salt and pepper, you’d think it would be almost impossible to separate them again. But using a little static electricity and a plastic spoon, it’s surprisingly simple.
Learn more: Separate Salt and Pepper at Science Kiddo
Explore static electricity with jumping goop

Difficulty: Easy / Materials: Basic
Your students have probably tried rubbing a balloon on their heads to create static electricity with their hair. This experiment is even cooler to see, as a mix of cornstarch and oil seems to leap off the spoon in front of their eyes!
Learn more: Static Electricity Goop at Frugal Fun for Boys and Girls
Predict the distance of lightning
Difficulty: Easy / Materials: Basic
This weather science experiment never fails to impress. Use a stopwatch to measure the difference between the flash and the sound of lightning and thunder, then calculate the distance between you and the strike.
Find your way with a DIY compass

Difficulty: Easy / Materials: Basic
Here’s an old classic that never fails to impress. Magnetize a needle and float it on the water’s surface—it will always point north.
Learn more: DIY Compass at STEAM Powered Family
Defy gravity with magnets and paper clips

Difficulty: Easy / Materials: Medium
Magnets are always a hit in the classroom. Use this simple experiment to discover more about gravity and the effects of magnets on metal objects.
Learn more: Magnet Gravity at Buggy and Buddy
More 3rd Grade Science Projects and Activities
These science experiments for 3rd graders explore all sorts of concepts, from the laws of motion to earth and planetary science and beyond.
Flick pennies to learn about inertia

Difficulty: Easy / Materials: Basic
This is one of those science experiments that kind of looks like magic, but it’s really all about the laws of motion. It might take a little practice to get the index card flick just right, but the results are always cool!
Learn more: Penny Inertia at Frugal Fun for Boys and Girls
See the temperature rise in a chemical reaction

Difficulty: Easy / Materials: Basic
When iron meets oxygen, rust forms. Use vinegar to remove the protective coat from steel wool and watch the temperature rise from the chemical reaction.
Learn more: Thermal Reaction at 123 Homeschool 4 Me
Float an iceberg

Difficulty: Easy / Materials: Basic
Use a balloon to make an iceberg, then float it in a dish of water to learn how much you can see above and below the waterline. Try experimenting with salt water to see how the density changes things.
Learn more: Icebergs at Science Sparks
Take a Play-Doh core sample

Difficulty: Easy / Materials: Basic
Learn about the layers of the Earth by building them out of Play-Doh. Then students can take a core sample with a straw. (Love Play-Doh? Get more learning ideas here.)
Learn more: Core Sampling at Line Upon Line Learning
Spin a disappearing color wheel
Difficulty: Easy / Materials: Basic
Color a paper disk with the six primary and secondary colors. Then thread a string through the middle and make it spin. The colors will seem to disappear!
Crystallize some pretty fall leaves

Difficulty: Easy / Materials: Medium
Every kid loves making crystals. In this 3rd grade science project, learn about supersaturated solutions by crystallizing some colorful fall leaves. Then use them as fall classroom decor!
Learn more: Salt Crystal Leaves at STEAMsational
Find a robot’s center of gravity

Difficulty: Easy / Materials: Basic
Print out, cut, and color this free paper robot. Then glue some coins to the back and have your students try to find its center of gravity!
Learn more: Balancing Robot at Buggy and Buddy
Make your own bouncing bubbles
Difficulty: Easy / Materials: Basic
Have your 3rd grade science students put on gloves and watch the bubbles bounce! Then encourage them to experiment with their own bubble solution. Try different soaps, mixing up the ratios to make the strongest bubble possible.
Project the stars on your ceiling

Difficulty: Easy / Materials: Basic
Use the video lesson in the link below to teach 3rd grade science students why stars are only visible at night. Then create a DIY star projector to explore the concept hands-on.
Learn more: Star Projector at Mystery Science
Blow bubbles inside bubbles inside bubbles
Difficulty: Medium / Materials: Basic
If there’s a more fun 3rd grade science project about surface tension than bubbles, we haven’t found it yet! Create a soap solution by using dissolved sugar and discover more about elasticity and volume as you blow bubbles inside bubbles inside bubbles …
Use water balloons to explore buoyancy

Difficulty: Easy / Materials: Basic
Fill water balloons with different solutions (oil, salt water, plain water, etc.) and place the balloons in a large bucket of water to see if they sink or float. This is a cool project to do with your 3rd grade science class on the playground on a sunny day.
Learn more: Balloon Density at 123 Homeschool 4 Me
Learn how water temperature affects density

Difficulty: Easy / Materials: Basic
Looking for a simple, quick, and colorful science experiment? This one just requires some mason jars, hot and cold water, and food coloring. Kids will be amazed at the results!
Learn more: Water Density Experiment at STEAMsational
Dissolve cups to learn about types of change

Difficulty: Easy / Materials: Basic
Teach your 3rd grade science class about the differences between physical and chemical changes with this quick and easy experiment involving Styrofoam cups.
Learn more: Dissolving Cups at The Owl Teacher
Turn crayons into rocks

Difficulty: Easy / Materials: Basic
Demonstrate the effects of heat and pressure on crayon shavings to explain the different types of rocks to students. It’s a colorful intro to geology!
Learn more: Crayon Rocks at The Owl Teacher
Stab a straw through a potato

Difficulty: Easy / Materials: Basic
Plastic straws may seem flimsy, but by using the power of air pressure, you can make one strong enough to stab all the way through a potato!
Learn more: Stab a Potato at KiwiCo
Shake up some ice cream

Difficulty: Easy / Materials: Basic
Get kids up and moving when they shake their way to ice cream, made from scratch using ice and plastic zipper bags! Talk about heating and cooling as well as condensation while you enjoy your snack.
Learn more: Ice Cream in a Bag at Mom of 6
Examine pine cones opening and closing

Difficulty: Easy / Materials: Basic
Pine cones can sense changes in humidity and adjust their scales in response. Gather several pine cones, glass containers, tweezers, and both hot and cold water to conduct a fun experiment to discover what makes pine cones open and close.
Learn more: Pine Cone Experiment at Parenting Chaos
If you liked these 3rd grade science projects, keep up the STEM enthusiasm with these fun and engaging 3rd grade math games.
Plus, sign up for our newsletters to get all the latest teaching tips and tricks, straight to your inbox!


